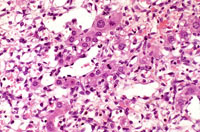
Ito cell proliferation
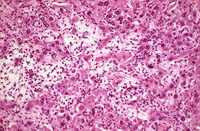
Ito cell proliferation

The Digitized Atlas of Mouse Liver Lesions

Much of the work carried out by DTT is in support of the National Toxicology Program (NTP), an interagency partnership of the Food and Drug Administration, National Institute for Occupational Safety and Health, and NIEHS.
Visit the NTP WebsiteLipomatous lesions (Ito cell tumors) are occasionally observed in mouse liver. While they may often resemble lipomas, some portions of these lesions may have a myxomatous appearance. They have been diagnosed as Ito cell lesions (Ito cell hyperplasia and Ito cell neoplasia) as well as lipomas. One case in the NTP archives that is morphologically similar to an Ito cell neoplasm was diagnosed as a sinusoidal cell sarcoma. The exact origin of these lesions is unknown but an origin from the vitamin A storing Ito cell is one possibility. Since it is not possible to identify vitamin A storing cells in H&S-stained sections, it may be more prudent to refer to these cells simply as perisinusoidal lining cells. The distinction between hyperplasia and neoplasia is not clear and the biological behavior of these lesions is not known. Metastases have not been noted, suggesting that these are benign proliferative lesions. These lesions are sometimes associated with extensive atrophy and destruction of hepatic parenchyma.
Dixon D, Yoshitomi K, Boorman GA, and Maronpot RR, 1994. “Lipomatous” Lesions of Unknown Cellular Origin in the Liver of B6C3F1 Mice. Vet.. Path. 31:173-182.
An Ito cell tumor that has replaced much of the normal hepatic parenchyma without distorting the normal contour of the liver; higher magnification shows fat-filled and stellate cells in the hepatic sinusoids.
The proliferating stellate cells have a myxomatous appearance in some areas and have caused atrophy of hepatic cords.
A relative discrete Ito cell tumor is present within this hepatic lobe; a higher magnification shows proliferation of stellate cells within the hepatic sinusoidal spaces.
This Ito cell tumor is comprised of a mixture of stellate cells and mature adipocytes.
More examples of Ito cell proliferation in B6C3F1 mice.